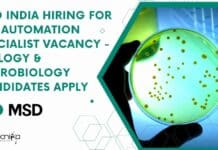
MSD India Hiring For Lab Automation Specialist Vacancy – Biology & Microbiology Candidates Apply MSD India Hiring

GNCT of Delhi ILBS Life Sciences Junior Research Fellow Recruitment
ILBS Life Sciences JRF Job For MSc, Applications Invited
ILBS Life Sciences JRF Job For MSc, Applications Invited. MSc Life Sciences Junior Research Fellow Jobs....
AIIMS Bathinda Cancer Project Recruitment, Applications Invited
AIIMS Bathinda JRF Job For Biotech, Biochem, Mol Bio & Life Sciences
AIIMS Bathinda JRF Job For Biotech, Biochem, Mol Bio & Life Sciences. MSc...
CSIR-TKDL Biological Sciences & Bioinformatics Project Associate (Patents) Recruitment
CSIR-TKDL Biological Sciences & Bioinformatics Project Associate Jobs
CSIR-TKDL Biological Sciences & Bioinformatics Project Associate (Patents) Recruitment. MSc / PhD Biological Sciences/ Bioinformatics Project Associate...
CSIR-IGIB Research Project Post Recruitment, Online Application Process
CSIR-IGIB Research Project Post Recruitment, Online Application Process
CSIR-IGIB Research Project Post Recruitment, Online Application Process. Natural sciences project associate job. Interested and eligible applicants...
IISER Mohali Biotech & Microbiology Research Fellow Job
IISER Mohali Biotech & Microbiology Research Fellow Job
IISER Mohali Biotech & Microbiology Research Fellow Job. MSc Biotechnology, Microbiology Junior Research Fellow job openings. Interested...
SARS COVID-2 Genome Sequencing Project Recruitment For Life Sciences at IISER Pune
Life Sciences Jobs IISER Pune Recruitment, Applications Invited
Life Sciences Jobs IISER Pune Recruitment, Applications Invited. BSc/ BTech/ MSc & MTech Life Sciences, PhD Biology...
AcSIR Admission Notification For January & August 2022 Session
AcSIR Admission Notification 2022 - Jan & Aug 2022 Session
AcSIR Admission Notification 2022 - Jan & Aug 2022 Session. Interested and eligible applicants can...
NIAB PhD Admission Program RSP-II 2021, Online Application Process
NIAB PhD Admission RSP-II 2021 Program, Online Application Process
NIAB PhD Admission RSP-II 2021 Program, Online Application Process. PhD Admission Program DBT-National Institute of Animal...
Biotecnika Times Newsletter 07.10.2021 DRDO-DFRL JRF To PhD, ACTREC JRF 2022 Online
Biotecnika Times - DRDO-DFRL JRF To PhD, ACTREC JRF 2022 Online
DRDO-DFRL JRF Leading to PhD & Research Associate Recruitment - Download Biotecnika App to...
NIBMG Research & Project Associate Jobs With Rs. 54,000 pm Pay, Apply Online
NIBMG Research Associate Jobs With High Pay, Apply Online
NIBMG Research Associate Jobs With High Pay, Apply Online. MSc & PhD Biochemistry/ Human Genetics/ Genetics/...
DRDO-DFRL JRF Leading to PhD & Research Associate Recruitment 2021
DRDO-DFRL JRF Leading to PhD & Research Associate Recruitment 2021
DRDO-DFRL JRF Leading to PhD & Research Associate Recruitment 2021. MSc & MTech Food Science,...
NCAAH-CUSAT Life Sciences DBT Funded Project Staff Recruitment
NCAAH-CUSAT Life Sciences DBT Funded Project Staff Recruitment
NCAAH-CUSAT Life Sciences DBT Funded Project Staff Recruitment. Interested and eligible applicants can check out all of...
Life Sciences Research Scientist Recruitment at MRU-UCMS
Life Sciences Research Scientist Recruitment at MRU-UCMS
Life Sciences Research Scientist Recruitment at MRU-UCMS. MSc Life Sciences research scientist job at multi-disciplinary research unit, University...
NII Vaccine Innovation Project Recruitment For Biological Sciences
NII Biological Sciences Job - Vaccine Innovation Project Recruitment
NII Biological Sciences Job - Vaccine Innovation Project Recruitment. Recruitment of BSc Biological Sciences candidates at...
AIMGATE 2022 – All India GATE Biotech & Life Science Test Series Launched –...
GATE Biotech Online Test
AIMGATE 2022 Online GATE Test Series Schedule Launched
The Graduate Aptitude Test in Engineering, commonly referred to as the GATE Exam,...